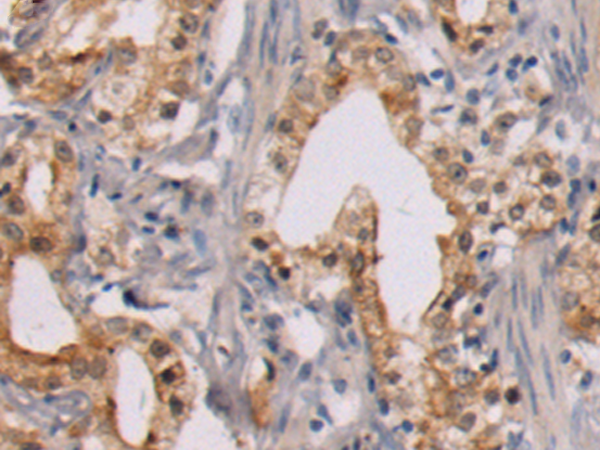

中文名稱(chēng): 兔抗MED13多克隆抗體
英文名稱(chēng): Anti-MED13 rabbit polyclonal antibody
別 名: ARC250; THRAP1; DRIP250; HSPC221; TRAP240
抗 原: MED13
儲(chǔ) 存: 冷凍(-20℃)
宿 主: Rabbit
反應(yīng)種屬: Human, Mouse
相關(guān)類(lèi)別: 一抗
標(biāo) 記 物: Unconjugate
克隆類(lèi)型: rabbit polyclonal
技術(shù)規(guī)格
|
Background: |
This gene encodes a component of the mediator complex (also known as TRAP, SMCC, DRIP, or ARC), a transcriptional coactivator complex thought to be required for the expression of almost all genes. The mediator complex is recruited by transcriptional activators or nuclear receptors to induce gene expression, possibly by interacting with RNA polymerase II and promoting the formation of a transcriptional pre-initiation complex. |
|
Applications: |
ELISA, WB |
|
Name of antibody: |
MED13 |
|
Immunogen: |
Synthetic peptide of human MED13 |
|
Full name: |
mediator complex subunit 13 |
|
Synonyms: |
ARC250; THRAP1; DRIP250; HSPC221; TRAP240 |
|
SwissProt: |
Q9UHV7 |
|
ELISA Recommended dilution: |
2000-5000 |
|
WB Predicted band size: |
239 kDa |
|
WB Positive control: |
K562 cells |
|
WB Recommended dilution: |
500-2000 |
購(gòu)物車(chē)
幫助
021-54845833/15800441009
